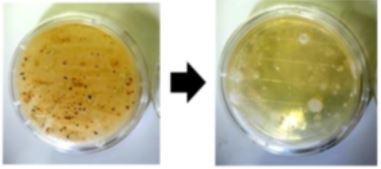
『衛生管理に入る前の除菌・洗浄』　靴底洗浄

農業・畜産支援に関連する気になるカタログにチェックを入れると、まとめてダウンロードいただけます。
臭 気対策・近隣配慮とは?課題と対策・製品を解説

目的・課題で絞り込む
カテゴリで絞り込む
スマート農業 |
次世代農業経営 |
畜産資材 |
農業 脱炭素・SDGs |
農業資材 |
その他農業・畜産支援 |

畜産(飼育管理)における臭気対策・近隣配慮とは?
各社の製品
絞り込み条件:
▼チェックした製品のカタログをダウンロード
一度にダウンロードできるカタログは20件までです。
畜産業界では、家畜の健康と生産性を維持するために、家畜舎内の環境管理が重要です。特に、CO2濃度、湿度、温度の適切な管理は、家畜の呼吸器系の健康や快適性に大きく影響します。不適切な環境下では、家畜のストレス増加、病気のリスク上昇、生産性の低下につながる可能性があります。EE850は、CO2濃度、湿度、温度を同時に測定し、換気システムの最適化に貢献します。5年間の校正が不要で、長期的な安定した測定が可能です。
【活用シーン】
・鶏舎、豚舎、牛舎などの家畜舎
・換気システムの制御
・家畜の健康状態モニタリング
【導入の効果】
・家畜の健康維持と生産性向上
・換気効率の最適化によるエネルギーコスト削減
・長期的な安定測定による運用コスト削減
酪農業界では、家畜排泄物の適切な処理と資源化が求められています。特に、悪臭対策や環境負荷の低減は重要な課題です。不適切な処理は、周辺環境への悪影響やコスト増につながる可能性があります。当社の畜ふん有機肥料堆肥化プラントは、畜糞を良質な有機肥料に変え、資源の有効活用を可能にします。
【活用シーン】
・酪農場での畜糞処理
・有機肥料の製造
・コスト削減
・環境負荷低減
【導入の効果】
・悪臭の抑制
・肥料コストの削減
・環境への貢献
・地域のイメージ向上
畜産業界では、家畜の健康管理と衛生的な環境維持が重要です。特に、悪臭の抑制や病原菌の繁殖を防ぐことは、生産性向上に不可欠です。しかし、従来の洗浄方法では、十分な効果が得られない場合や、手間がかかるという課題があります。YJノズルは、マイクロ・ナノバブルを発生させることで、畜舎内の洗浄や消毒の効果を高め、衛生環境を改善します。
【活用シーン】
・畜舎の洗浄
・排水処理
・家畜の飼育水の衛生管理
【導入の効果】
・悪臭の軽減
・病原菌の抑制
・家畜の健康維持
食肉加工場では、処理過程で発生する悪臭が周辺環境や作業環境に影響を与えることがあります。特に、硫化水素やメチルメルカプタンといった腐敗臭は、近隣住民からの苦情や作業員の健康問題を引き起こす可能性があります。これらの悪臭は、企業のイメージを損なうだけでなく、従業員の士気低下にもつながりかねません。デオキープ(R)は、これらの問題を解決するために開発されました。
【活用シーン】
・食肉加工場の汚泥処理施設
・排水処理施設
・脱水ケーキ保管場所
【導入の効果】
・周辺住民からの悪臭苦情の減少
・作業環境の改善
・従業員の健康と安全の確保
・企業イメージの向上
養鶏業界では、飼料の効率的な利用と豚の健康的な成長が求められます。リキッド飼料は栄養価が高く豚の食欲を増進させる効果がありますが、食品残渣による閉塞が課題となることがあります。この閉塞は、飼料供給の遅延や、豚の成長への悪影響を引き起こす可能性があります。当社の破砕ポンプは、リキッド飼料製造ラインに設置することで、食品残渣を細かく破砕し、閉塞を防止します。これにより、飼料の安定供給と豚の健康的な成長をサポートします。
【活用シーン】
・リキッド飼料製造ライン
・食品残渣の多い飼料の利用
【導入の効果】
・貯留槽での分離防止
・飼料の栄養価向上
・豚の食量増加
・食品産業廃棄物の削減
畜産業界では、家畜の排泄物や飼料の腐敗などにより、悪臭問題が深刻化しています。近隣住民からの苦情や、作業環境の悪化は、経営上の大きな課題です。特に、悪臭は作業員の健康被害や、家畜の生育環境にも悪影響を及ぼす可能性があります。YJ-MB曝気装置は、マイクロ・ナノバブル技術により、悪臭の原因物質を分解し、臭気問題を根本から解決します。
【活用シーン】
・畜舎の調整槽、曝気槽
・汚水処理施設
・堆肥場
【導入の効果】
・悪臭の低減
・作業環境の改善
・近隣トラブルの減少
・家畜の生育環境改善
農業、特に家畜排泄物処理の現場では、メタンガスなどの可燃性ガスが発生し、爆発や火災のリスクがあります。安全な作業環境を確保するためには、ガス漏れを検知し、適切な対策を講じることが不可欠です。N87Exシリーズ防爆型ガスポンプは、可燃性ガス環境下での回収作業において、安全性を確保するために設計されています。IECEx /ATEX認証を取得しており、信頼性の高いポンプソリューションを提供します。
【活用シーン】
・可燃性ガスを含む家畜排泄物の回収
・ガス漏れ検知システムの構築
・爆発性雰囲気下でのガスサンプリング
【導入の効果】
・可燃性ガス環境下での安全な作業の実現
・ガス漏れによる事故のリスク低減
・作業効率の向上
畜産業界では、家畜の糞尿処理から発生する汚泥の適切な処理が求められます。特に、悪臭の抑制、環境への負荷軽減、そして効率的な汚泥削減が重要です。不適切な汚泥処理は、環境汚染や近隣住民とのトラブルにつながる可能性があります。当社のデカンタ型遠心脱水機は、目詰まりしにくく、少ない洗浄水で運用できるため、畜産汚泥の効率的な処理に貢献します。
【活用シーン】
・畜産農家における糞尿処理
・家畜排せつ物処理施設の汚泥脱水
・バイオガスプラントにおける消化液の脱水
【導入の効果】
・汚泥量の削減
・悪臭の低減
・ランニングコストの削減
・環境負荷の低減
畜産業界では、家畜の健康と生産性を維持するために、適切な環境管理が求められます。特に、家畜小屋内のCO2濃度は、換気の効率や家畜の呼吸器系の健康に大きく影響します。高濃度のCO2は、家畜のストレスや病気を引き起こす可能性があります。EE820 CO2トランスミッターは、過酷な環境下でも正確なCO2測定を行い、換気システムの最適化を支援します。
【活用シーン】
・家畜小屋
・鶏舎
・豚舎
・牛舎
【導入の効果】
・家畜の健康維持
・生産性の向上
・換気効率の最適化
・コスト削減
肥料製造業界では、製造プロセスにおける粉塵や臭気の発生が課題となっています。これらの問題は、作業環境の悪化だけでなく、周辺環境への影響も懸念されます。環境負荷を低減し、持続可能な製造体制を構築するためには、密閉された搬送システムが不可欠です。チューブラコンベヤは、粉体や粒体を密閉した状態で搬送することで、これらの課題を解決します。
【活用シーン】
・肥料原料の搬送
・製造工程における粉体の移動
・環境規制への対応
【導入の効果】
・粉塵・臭気漏れを防止し、作業環境を改善
・周辺環境への負荷を低減
・コンプライアンス遵守
畜産農家では、畜舎からの悪臭が周辺住民からの苦情や作業環境の悪化につながる可能性があります。特に、家畜の排泄物や飼料の腐敗臭は、硫化水素やメチルメルカプタンなどの原因物質によって発生し、対策が求められます。デオキープ(R)は、これらの腐敗臭を化学反応と微生物抑制作用で除去し、悪臭を低減します。
【活用シーン】
・畜舎
・堆肥舎
・汚水処理施設
【導入の効果】
・周辺住民への悪臭苦情対策
・作業環境の改善
・臭気による家畜へのストレス軽減
養鶏業界では、鶏糞の適切な処理と有効活用が課題となっています。悪臭や環境汚染のリスクを軽減しつつ、肥料としての価値を高めることが求められます。当社の有機肥料化プラントは、鶏糞を効率的に堆肥化し、高品質な有機肥料を製造することで、これらの課題を解決します。
【活用シーン】
・鶏糞の堆肥化による悪臭・害虫対策
・有機肥料の製造によるコスト削減
・循環型農業への貢献
【導入の効果】
・鶏糞処理コストの削減
・良質な有機肥料の生産
・環境負荷の低減
『Cモード』は、堆肥原料の混合作業を自動化する装置です。
ローダーから直接、原料と副資材を投入する事ができるため省スペース。
比重の異なる原料や、ローダーでは混合しづらい高分子汚泥でも、
短時間に均一に混合することができます。また、従来の処理方法に比べ
圧倒的な省コスト、省エネルギーを実現します。
Cモードの特長やメリット、導入事例などを掲載した資料を進呈中です。
【掲載内容】
■Cモードとは
■導入メリット
■導入事例
■オプション 他
※詳しくはPDF資料をご覧いただくか、お気軽にお問い合わせ下さい。
『RA-X(ラックス)』は、水分に関係なく確実撹拌、悪臭・汚水がなく、完全食品循環サイクルを実現する汚水同時処理機です。高気性高温発酵のため、腐敗せず短期間での堆肥化を実現し、100トン以上の食品残渣を約1~3ヶ月で堆肥化。また、メンテナンスが簡単で維持費が安く経済的なうえ、撹拌時の温度低下が少なく省エネ発酵が可能です。
【特長】
■特許第367252
■固形物・汚水の同時処理が可能
■寒冷地でも高温発酵処理が可能
■移動中の発酵臭飛散が少ない
■様々な事業形態に対応
■温室効果ガス削減が可能
※詳細は資料請求して頂くか、ダウンロードからPDFデータをご覧下さい。
『バイオトップサンド』は、ペットの臭気環境や水環境の改善と保全に
効果のある環境改善資材です。
ペットの餌に添加してご使用いただくことで糞による臭気を低減。
餌の量に対して、約0.1%の当製品を添加してください。
また、熱帯魚やメダカ、金魚、錦鯉など鑑賞魚の水環境も改善。
餌に添加してご使用いただくことで糞による水質汚濁を低減します。
【目的と効果】
■畜糞の臭気低減と発酵促進による肥料化促進
■魚類などの糞による水質汚濁の低減と水質保全および臭気の低減
※詳しくはPDF資料をご覧いただくか、お気軽にお問い合わせ下さい。
『ことりソリューション』は、農場の常在菌を活性化し、増殖、
発酵へと促すことができる堆肥発酵特殊酵素剤です。
糞を70%以上微生物消化することで大幅な労力、経費を軽減。
また、環境改善に同処理を行うことで臭気、ハエの発生を
減少させることができます。
【メリット】
■畜糞を削減することにより、堆肥販売の費用負担を低減
■畜糞発酵処理の臭気を極力低減することで、近隣住民対策及び、
従業員の方の作業環境の改善が期待できる
■堆肥発酵時のランニングコストを軽減できる
※詳しくはPDF資料をご覧いただくか、お気軽にお問い合わせ下さい。
『コンポDシリーズ』は、簡単な処理工程から良質な有機質肥料を
生み出す発酵堆肥化処理システムです。
酪農牛糞は、水分が多く発酵エネルギーが少ないため、水分調整を行い
長時間堆積して処理する方法が取られてきましたが、当製品では
発酵エネルギー不足を補うことで、短時間に効率よく処理できます。
また、生の畜糞を直接投入することができ、投入・取出時間以外は
無人で運転を行うため、人員コスト削減に貢献します。
【特長】
■生の畜糞を直接投入可能
■操作時間を大幅短縮
■一括排気で脱臭対策が簡単
■屋外設置が可能
■大量処理の一槽発酵槽
■わずかなスペースで設置可能
■耐久性、断熱性を重視した構造
※詳しくは、お気軽にお問い合わせ下さい。
『Tシリーズ』は、高効率設計で動力が小さく電力費を抑えることが
可能なヘイキューブ粗砕機です。
低速回転に設計され騒音と振動が少なく環境改善に繋がります。
シンプルでコンパクトな設計のため、固定式、移動式いずれでも設置可能。
本機の特長として運転中でもヘイキューブ塊の破砕状態をハンドル操作で
簡単に調整することが出来ます。
【特長】
■省電力化に貢献
■より快適な環境整備
■設置場所を選ばない設計
■運転中でも調整可能
■成牛・子牛用の両方に対応
※詳しくはPDF資料をご覧いただくか、お気軽にお問い合わせ下さい。
○ 畜糞や汚泥を強力に分解、悪臭を取り除きます。
○ 堆肥の発酵が促進され、短期間で良質の堆肥ができます。
○ アンモニア、硫化水素などの有害ガスの発生を抑えます
当社では、「クプアス」を原料とした『森のクプアス 畜産用』を
取り扱っております。
クプアスに水分を添加すると消臭作用が始まるのが大きな特長で、
牛や豚、鳥(卵)畜産業舎の臭いを軽減する効果が期待できる製品。
また、当製品は、皮と実をミックスしたもので、ビタミン、消臭作用を
持った畜産用となっております。
【特長】
■水分を添加すると消臭作用が始まる
■牛、豚、鳥(卵)畜産業舎の臭いを軽減
■肉のクオリティアップも期待できる
※詳しくはPDFをダウンロードしていただくか、お気軽にお問い合わせください。
『農畜用炭素』は、無機成分を数%含有し、特にカルシウムを多く含むため、
卵殻は固くなり、ヒビ割れが少なくなります。
PHが8前後の弱アルカリ性のため、家畜の酸性体質をアルカリ性にし、
不要な脂肪の付着を軽減。
また、卵質をアルカリ性にするため、鮮度が向上し、卵黄が固くなります。
【特長】
■PHが8前後の弱アルカリ性のため、不要な脂肪の付着を軽減
■鮮度が向上し、卵黄が固くなる
■卵殻は固くなり、ヒビ割れが少なくる
■内部表面積が大きく300~400m2/gもある
■排泄された糞尿の臭いが減少
※詳しくはPDF資料をご覧いただくか、お気軽にお問い合わせ下さい。
牛糞の発酵力が強い乳酸菌を主体とした微生物を独自の製法により高濃度培養しているため、分解速度が速く良質な有機肥料を作ります。また、冬で外気温が低く堆肥が発酵しない場合や、一度発酵に失敗した堆肥の再発酵としても最適です。
高濃度培養のため原液から1000倍程度まで希釈して使用できて経済的です。
人畜無害で安全性が高い乳酸菌を主体とした微生物を厳選して培養しており、マウスに飲ませる安全性試験による急性経口毒性試験によって安全性も証明されており安心してご使用いただけます。
また、発酵菌の希釈液を家畜の飲料や飼料に混ぜて発酵させてから与えている畜産農家の方もいて、乳酸菌等の整腸作用による健康維持と糞尿の臭いが軽減によって大変喜ばれています。
発酵時に悩まされる悪臭であるアンモニアや硫化水素等も発酵促進剤に含まれる酵素や微生物の力によって軽減しながら理想的な発酵が可能になります。
乳酸菌で高 温バイオ発酵、畜産糞尿の堆肥化でメタンガスを出さない温暖化対策でSDGsに貢献出来ます。
養豚(縦型)へ、バイオトップサンド(BTS)を実施した例についてご紹介します。
豚糞臭気をおが粉に接触、非常に強い臭気が問題でした。
豚糞臭気を当製品(ペレット)に接触させ、臭気が低減しました。
5年以上も臭気の低減を維持しているとのことです。
また、掲載カタログにて、そのほかの実施例もご紹介しておりますので、
是非、ダウンロードしてご覧ください。
【概要】
■課題
・豚糞臭気をおが粉に接触
・非常に強い臭気が問題(NH4値:700~1300ppm)
■結果
・臭気が低減
※詳しくはPDF資料をご覧いただくか、お気軽にお問い合わせ下さい。
『ECOCON719』は、鶏舎・豚舎等家畜生産設備用循環冷却装置です。
本装置の機能は、自然界の有効資源をフル活用。四季を通して、
暑熱化対策、寒冷対策、有害ウイルス除去を可能にしました。
また、Wi-Fi機能搭載で遠隔操作、管理、データ収集が出来る
オプションもご用意しております。
【特長】
■地熱交換(地下水)方式
■外気取り入れ方式
■送風量・送風圧が大きい
■吸気側を変更する事で、循環式にも使用できる
■加湿器追加で温風も発生できる(18~20℃)
※詳しくはPDF資料をご覧いただくか、お気軽にお問い合わせ下さい。
『“そよ風”』は、生ごみや野菜くずの腐敗臭、豚舎・牛舎・養鶏場の糞尿による
悪臭を除去する安全性の高い、様々な臭気に効果のある消臭・除菌剤です。
生ごみや糞尿に直接スプレー又はふりかけることにより腐敗臭や悪臭を消臭し、
更に腐敗を防ぎ、抗菌成分が菌の繁殖をおさえます。
また、希釈媒体にエタノール等を使用することも可能で、用途や目的に合わせて
自由に配合できます。
【特長】
■安全性が高い
■腐敗臭や悪臭を消臭
■抗菌成分が菌の繁殖を抑制
■希釈媒体にエタノール等を使用することも可能
■用途や目的に合わせて自由に配合できる
※詳しくはPDF資料をご覧いただくか、お気軽にお問い合わせ下さい。
ニオイックス株式会社の消臭剤噴霧装置『NIOIXシステム』を導入した
堆肥製造施設への消臭対策事例をご紹介します。
有機質肥料の製造ライン排気です。自社の天然有機質肥料のみを使用して、
農作物を栽培する新しい試みに取り組んでいる企業様です。
日本の農業の一助になれるよう企業理念である“すべてのニオイを解決したい”を
基に挑戦していきたいと考えております。
さまざまなニオイに消臭効果を発揮し、即効性・安全性を兼ね備えた消臭液
「夢・消太SH200」は好適。香質・臭気強度や排気風量により噴霧BOXを
設置し、接触効率を上げ消臭効果を最大限発揮できるように設計します。
まずは、消臭デモテストによる消臭液の有効性・効果を体感したいという方は、
ご遠慮なくお問い合わせください。ニオイのことなら何でもご相談ください。
※詳しくはPDF資料をご覧いただくか、お気軽にお問い合 わせ下さい。
※消臭液のサンプルを無料進呈しています。
ご要望の方は、下記お問い合わせボタンよりご依頼ください。
真空・脱気シーラーの真空包装のサンプルづくり 飼料編を紹介します。
家畜用の飼料を脱気包装するということで、袋の中には「おから」や「ぬか」その他何種類も入っており、脱気包装した状態で嫌気性の菌による発酵を待ちます。
通常、発酵すると匂いが気になりますが、袋で包装しているので匂いは気になりません。
包装の際きつめに脱気包装し、発酵が進むにつれ徐々に膨らみ菌は元気に活動している様です。
【概要】
○家畜用の飼料を脱気包装する
○脱気包装した状態で発酵を待つ
○袋内で発酵するため匂いが気にならない
○発酵が進むにつれ包装が徐々に膨らむ
○菌は元気に活動している
詳しくはお問い合わせ、またはカタログをダウンロードしてください。
ビー・シー・オーでは、畜産にご活用いただける環境クリーンシステム
『BCO ハピネス』を取り扱っております。
ハピネス水を飲ますことにより、牛舎全体及び周辺の臭気対策が可能。
排水処理が良くなり、臭気及び排水処理水質が良くなります。
豚舎の排水浄化に活用した例では、曝気槽に微生物が繁殖し、有機物の
分解が活発に行われています。年間の汚泥の量が減り、引き抜きの回数が
減少しました。
【特長】
■全体の臭気の改善
■成育促進(品質の向上)
■排水の改善(コスト削減)
※詳しくはPDF資料をご覧いただくか、お気軽にお問い合わせ下さい。
工場増設に伴う排水量増加の為、既設の処理水槽の散気装置をアクアブラスターに変更して、処理能力アップを行った。
調整槽と曝気槽にアクアブラスターを設置することで、水槽サイズを増やすことなく、10~20%の負荷増を受け入れることに成功。
更に、加圧浮上装置を使用することなく処理が行えるようになった。
ベストエイドは、多肉植物から抽出した天然の製品です。だから安心。しかもローコスト。簡単な作業で、悪臭や汚れを自然に消滅させ、下水や汚水をやさしく海に還します。
豚糞の発酵力が強い乳酸菌を主体とした微生物を独自の製法により高濃度培養しているため、分解速度が速く良質な有機肥料を作ります。また、冬で外気温が低く堆肥が発酵しない場合や、一度発酵に失敗した堆肥の再発酵としても最適です。
高濃度培養のため原液から1000倍程度まで希釈して使用できて経済的です。
人畜無害で安全性が高い乳酸菌を主体とした微生物を厳選して培養しており、マウスを用いた安全性試験による急性経口毒性試験によって安全性も証明されており安心してご使用いただけます。
また、発酵菌の希釈液を家畜の飲料や飼料に混ぜて発酵させてから与えている畜産農家の方もいて、乳酸菌等の整腸作用による健康維持と糞尿の臭いが軽減によって大変喜ばれています。
発酵時に悩まされる悪臭であるアンモニアや硫化水素等も発酵促進剤に含まれる酵素や微生物の力によって軽減しながら理想的な発酵が可能になります。
乳酸菌で高温バ イオ発酵、畜産糞尿の堆肥化でメタンガスを出さない温暖化対策でSDGsに貢献出来ます。
当カタログは、愛知電機株式会社が取り扱う畜舎用換気扇をご紹介しています。
高効率ブラシレスDCモータと新型ブレードの採用により省エネ効果が向上した
「1m換気扇」をはじめ、「60cm換気扇」「専用コントローラ」など多数掲載。
ぜひ、ご一読ください。
【掲載製品】
■1m換気扇
■60cm換気扇
■専用コントローラ(別売)
※詳しくはPDF資料をご覧いただくか、お気軽にお問い合わせ下さい。
『コンポSシリーズ』は、使いやすい一槽式蓄糞処理機で、簡単な
処理工程から有機肥料を生み出す発酵堆肥化処理システムです。
縦型の発酵槽で場所を取らないため、わずかなスペースで設置でき、
屋外設置も可能となっています。
また、生の畜糞を直接投入することができ、投入・取出時間以外は
無人で運転を行うため、人員コスト削減に貢献します。
【特長】
■生の畜糞を直接投入可能
■操作時間を大幅短縮
■一括排気で脱臭対策が簡単
■大量処理の一槽発酵槽
■製品は良質な有機質肥料
■耐久性、断熱性を重視した構造
※詳しくは、お気軽にお問い合わせ下さい。
『畜産(鶏/豚/牛)向け次亜塩素酸水(炭酸次亜水) 噴霧システム』は、
炭酸次亜水を噴霧することにより、畜産経営に直結する問題である
防疫・消臭・暑熱対策に効果を得られます。
<防疫>
感染症の原因となるウイルス・細菌を不活性化することが可能です。
<消臭>
畜産特有のニオイを強力消臭します!
<暑熱対策>
夏場の暑さ対策・冬場の乾燥対策に効果があり、空間噴霧することにより、
夏場は畜舎内の冷却を行い舎内温度を下げ、冬場は湿度を保持し乾燥を
防ぎます。
デモ機もありますので、是非お問合せ下さい。
※詳しくはPDFをダウンロードしていただくか、お気軽にお問い合わせください。
画像にて菌の洗浄効果を実験したものをご紹介しております。
電解水生成装置『KEW-A009』は、2隔膜3室型の電解セルを使用して、水と精製塩から、陽極側に酸性電解水(次亜塩素酸水)を、陰極側にアルカリ性電解水(水酸化ナトリウム水溶液)を生成する装置です。
※詳しくはPDFをダウンロードしていただくか、お気軽にお問い合わせください。
当資料では、サトウキビから採れた精糖蜜を栄養源に、パン酵母・
ヨーグルト用乳酸菌・納豆菌を培養した微生物資材「えひめAI-1」の
『堆肥発酵への効果』をグラフでご紹介しています。
当製品を生ゴミ、畜糞等の堆肥原料に0.2~0.6%(原料体積比)混ぜ込むことで、
堆肥製造工程における臭気軽減、発酵促進効果などが期待できます。
【掲載内容】
■生ごみの堆肥化
・堆肥発酵中の臭気濃度
・堆肥発酵中のアンモニア濃度
・堆肥発酵中の温度推移
・固形物分解の比較
※詳しくはPDF資料をご覧いただくか、お気軽にお問い合わせ下さい。
『60cm/1m換気扇』は、高効率ブラシレスDCモータと新型ブレードの
採用により省エネ効果が向上した製品です。
防水構造のため水圧5MPaまでの高圧洗浄が可能。ボタン配置がわかりやすく、
風量の設定・操作が簡単です。
また、インバータをモータに内蔵することにより、耳障りな音やノイズを
大幅に低減しました。
【特長】
■電気代の大幅削減
■ゆらぎ運転により更に省エネ
■800m3/min(1m換気扇)、170m3/min(60cm換気扇)の大風量
■気になる電気的ノイズを低減
■防水構造で高圧洗浄可能
■表示が見やすく、操作も簡単
※詳しくはPDF資料をご覧いただくか、お気軽にお問い合わせ下さい。
約1億年以上前に地球上に存在した植物や藻類などを始めとした有機物が
長い年月を経て腐植を繰り返し石炭や石油になる手前の泥炭から
約0.2%抽出される貴重な有機酸が『フルボ酸』です。
キレート作用で、ミネラルを細かくイオン化。
吸収率を97%と高い数値まで高めます。
抗菌作用、酵素活性化の促進、植物の成長を促進、
消臭作用といった効果があると言われています。
【特長】
■抗菌作用
■酵素活性化の促進
■消臭作用
■ミネラルを細かくイオン化して吸収率を97%と高い数値まで高める
※詳しくはPDF資料をご覧いただくか、お気軽にお問い合わせ下さい。
ベストエイドは植物のアロエより抽出されたサポニン液が主たる成分であり、他の植物性サポニンと比較してもその効果は非常に優れております。
ベストエイドは自然に優しい生薬で作られており、自然界の生態サイクルを破壊することなく、好気性微生物・嫌気性微生物・土壌微生物の活動を助けると同時に目的に合致した細胞の増殖を行うことにより、微生物に加わるストレスの緩和、微生物による臭気の除去、また、油脂分解の促進等に、顕著なる効果があります。
牧草用シート「B・Rシート」は、農業用フィルムで長年培った実績と技術を持つ昭和パックスが設計したサイレージに最適のシートです。特殊原料を用いた3層構造により空気を遮断し、良質なサイレージを線産することができます。簡易作成、設置場所の制約が少ないスタックサイロ・バンガーサイロに広く利用されています。詳しくはカタログをダウンロードしてください。
家畜用のエサの原料を計量する時の排気設備の導入事例を
ご紹介いたします。
家畜用飼料製造において、家畜用のエサの原料の計量時に粉塵が
発生するという問題がありました。
製造環境に合わせて特別対応品を提案し、囲い式フード付き作業台と
防爆仕様集塵機を導入したことで作業環境が綺麗になりました。
【事例概要】
■導入経緯
・家畜用のエサの原料の計量時に粉塵が発生するため、困っていた
■改善内容
・囲い式フード付き作業台と防爆仕様集塵機を導入したことで作業環境が
綺麗になった
※詳しくはカタログダウンロードボタンより事例付き総合カタログをご確認ください。
『せっかいSRS』は、特殊樹脂に消石灰を混ぜて使う、塗るだけで
抗菌の問題が解決する塗布材です。
消石灰と同じ効果があり、高い抗菌性能(高アルカリ)があります。
また、日々の消石灰をまく時間と手間がいらず、余計な人手が必要
なくなるため、消石灰散布にかけるコストが圧倒的に安くなります。
【特長】
■長期間効果が持続
■雨でも流れない
■高い耐久性
■高い断熱性能
■安価な利用コスト
※詳しくはPDFをダウンロードして頂くか、お気軽にお問い合わせ下さい。
『D2000 シリーズ』は少ない面積で大量の処理ができるスクープ式
発酵乾燥機です。
移動台車を使用し、複数槽を自動的に行います。また、自動タイマー
運転により無人での運転も可能です。
少ない面積で大量の処理ができ、完成した堆肥は細粒状になり、流通
しやすい製品になります。
また、時間節約のため、帰りの速度は2倍速、4倍速が可能です。
【特長】
■大量処理に適した装置
■時間節約が可能
■無人での運転が可能
※詳しくはカタログをご覧頂くか、お気軽にお問い合わせ下さい。
『空間スーパーとるとる』は、様々な種類の細菌を除菌する養鶏場の
防疫対策品です。
強力な消臭効果で、特に鶏糞の臭いに効果絶大。
応接室などに設置すれば、外部からの細菌もシャットアウトできます。
また、ワクモ等にも効果が期待できる「空間スーパーとるとる500超強力用」や、
人体に影響が出ない低濃度でよく効く常用タイプの「空間スーパーとるとる400」
などもご用意しています。
【特長】
■強力な消臭効果で、特に鶏糞の臭いに効果絶大
■様々な種類の細菌を除菌
■他の薬品と比べて低濃度で作用する
■サビが出にくいなど機械にも配慮
※詳しくはPDF資料をご覧いただくか、お気軽にお問い合わせ下さい。